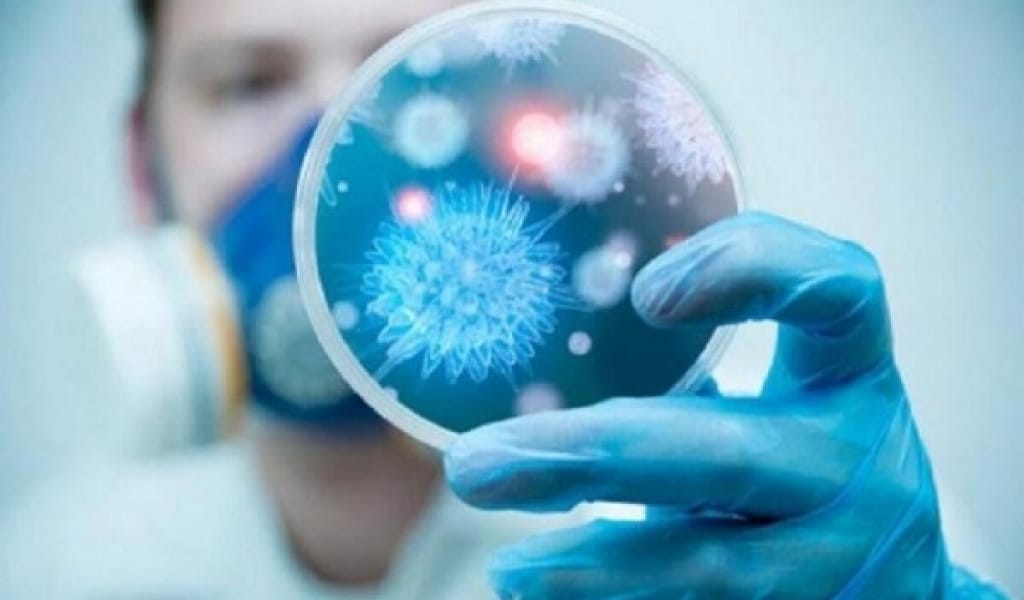
КОРОНАВИРУС ҚАЙТА КҮШЕЙДІ. БАС САНИТАР СЕГІЗ ТҮРЛІ КЕҢЕС ҰСЫНДЫ

КОРОНАВИРУС ҚАЙТА КҮШЕЙДІ. БАС САНИТАР СЕГІЗ ТҮРЛІ КЕҢЕС ҰСЫНДЫ
Алматы облысының Бас мемлекеттік санитариялық дәрігері коронавирустың таралуына жол бермеу мақсатында тұрғындарға 8 түрлі кеңес ұсынды. Олар мынадай:1.Адамдардан қауіпсіз қашықтықта болыңыз...